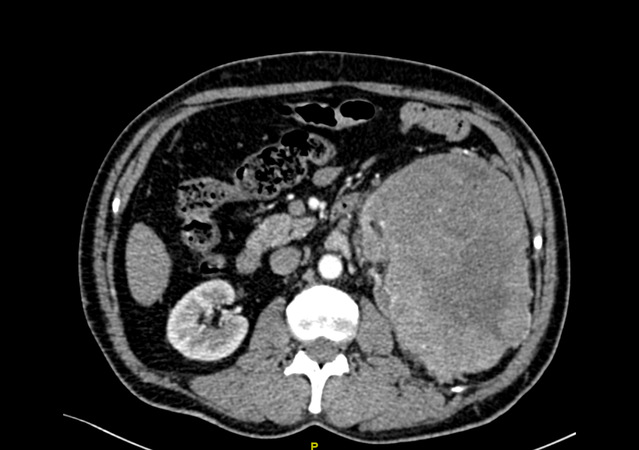

今年的4月1日,吴江的陈先生突然出现左腰痛。过了半天的时间,腰痛的症状非但没有缓解,反而进一步出现了小便不能自解的情况。于是,陈先生急忙赶到当地医院,予留置导尿管解除小便梗阻后发现,尿液呈血性。为了做进一步的治疗,焦急的陈先生赶到了金沙娱乐城app
泌尿外科就诊。
经过CT等检查,发现陈先生的左边肾脏上长了一个巨大的肿瘤,大小约16.6cm*11.1cm,也正是因为这个原因,导致了腰痛、血尿、排尿困难等一系列症状。
金沙娱乐城app 泌尿外科团队仔细分析了患者的病情、症状以及影像学检查,发现陈先生体内的这一颗“定时炸弹”比既往所处理过的任何一例肾脏肿瘤都要庞大,而且已经充满了患者的后腹腔,更为棘手的问题在于肿瘤恶性可能极大,供养这颗肿瘤生长的血管,也密密麻麻的盘曲在肿瘤周围,给手术治疗带来了极大的困难。如果按照既往的治疗方案,对于如此巨大的肾脏肿瘤,而且同时合并肿瘤出血带来的粘连等一系列困难,往往选择开放手术,也就是老百姓口中的“开大刀”。但是众所周知,开放手术存在切口长、手术创伤大、术后恢复缓慢以及术后并发症多等诸多缺点。思虑再三,经过泌尿外科科内讨论后,最终决定给陈先生实行了腹腔镜下微创手术,减少手术带来的损害及痛苦。
4月7日,经过团队成员的共同努力,陈先生顺利进行了腹腔镜下的左肾及肿瘤切除术。为了更准确的评估病情以及减少复发转移的风险,术中还同时进行了淋巴结清扫术,术后标本称重达1600克。有赖于微创手术的优势,手术之后,陈先生恢复良好。手术后的病理结果证实:左肾肿瘤为肾嫌色细胞癌,淋巴结未见明显转移,通过手术,已将肿瘤完整的切除,而患者也将有一个比较好的预后。

解密肾脏肿瘤
肾脏肿瘤可分为良性肿瘤和恶性肿瘤两大类,较小的良性肿瘤往往不需要特殊处理,但当肿瘤增大,或者合并有出血、感染等情况时,也需要泌尿外科进行手术治疗来干预处理;而恶性肿瘤以肾细胞癌多见,也就是常常听说的“肾癌”,当前肾细胞癌的发病率占成人恶性肿瘤的2%-3%,在泌尿系统肿瘤中位于第三位,仅次于前列腺癌和膀胱癌。尽管排行第三,但其致死率却排名泌尿系统恶性肿瘤第一位。目前,对于肾癌的病因尚无明确定论,但其的发生与遗传、吸烟、肥胖、高血压以及抗高血压药物等有关。肾癌的治疗方式上,外科手术治疗依旧是局限性和局部进展性肾癌的**方式,而对于发现较晚的晚期肾癌患者,在内科治疗的同时,仍可根据患者的自身情况采取减瘤性质的肾切除术。
相较于传统的开放手术方式,微创手术具有创伤小、恢复快等众多“先天”优势,对于患者而言更容易接受。目前,金沙娱乐城app 泌尿外科已常规开展腹腔镜下肾脏的各类微创手术,按照患者具体情况,采用经腹腔或经后腹膜等各种途径,制定最适合患者个人的手术方案,最终达到治愈的目的。
泌尿外科 马峥